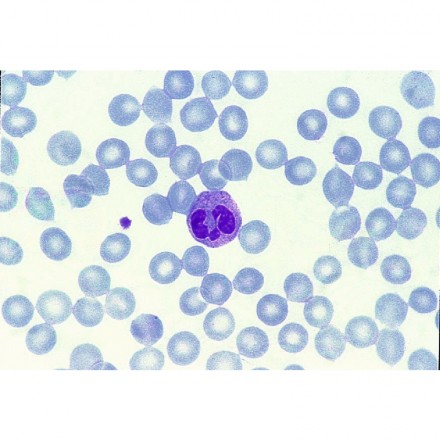

Descriptif
Les préparations NUBLAT sont l’objet de soins attentifs et de contrôles rigoureux, tout au long de leur fabrication :
– Coupe très fine, pour permettre un examen facile,
– Coloration légère, pour mettre en évidence les différents éléments.
Caractéristiques techniques
| Coloration | Hémalun Eosine |
|---|---|
| Thématiques | Sang |
| Typologie de produits | Objets à observer |
[